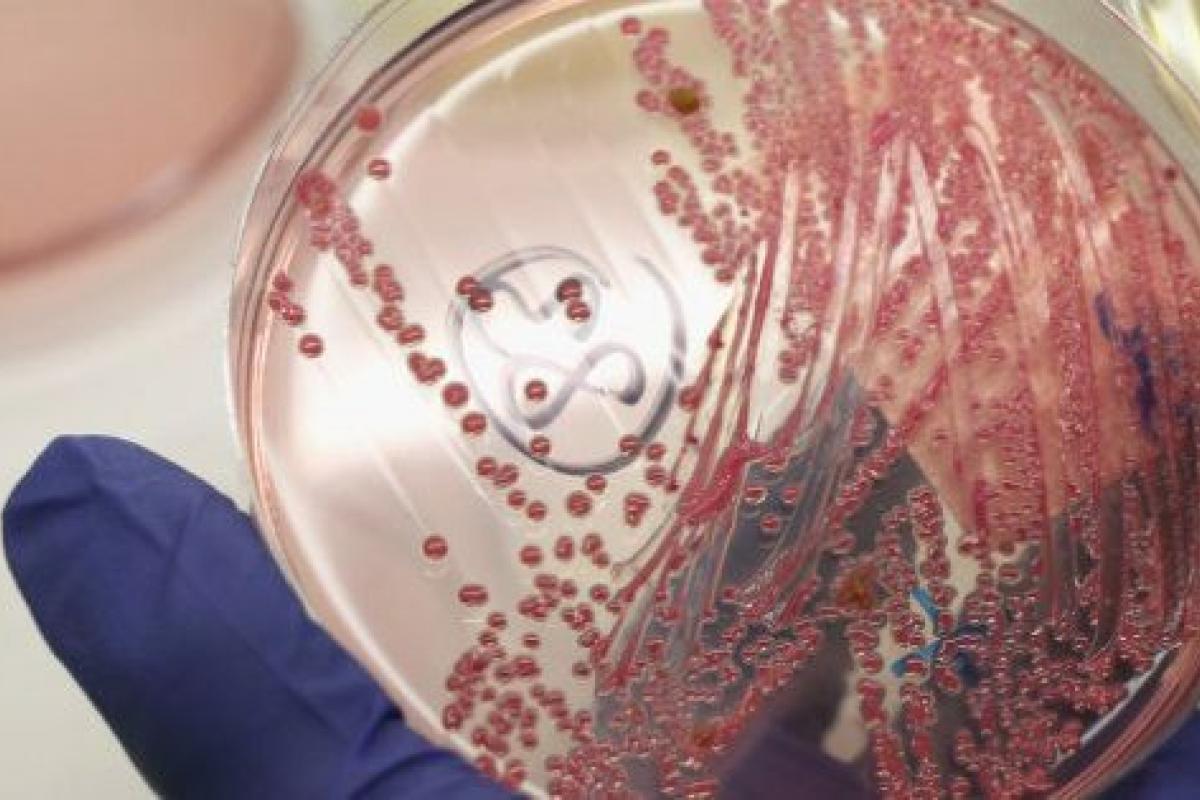

Superbacterias sin tratamiento: Reino Unido llama a la acción global
En EEUU se habla estos días de una nueva "bacteria pesadilla" en hospitales, resistente a los antibióticos. Se llama carbapenem-resistant Enterobacteriaceae (CRE) y es letal en el 50% de los casos en infecciones hospitalarias porque ha aumentado su resistencia a los antibióticos más potentes.
Los científicos y responsables de salud han vuelto a llamar la atención sobre las superbacterias que se escapan a tratamientos.
La resistencia a los antibióticos es una "amenaza catastrófica" para la medicina y puede suponer que pacientes sometidos a cirugías con riesgo bajo mueran por infecciones que ya no pueden ser tratadas con los medicamentos existentes, por la mutación de las bacterias. Es la llamada de atención que llega de la asesora médica del Gobierno del Reino Unido, Sally Davies.
La experta ha reclamado este lunes un acción global en la lucha contra los antibióticos para encontrar una alternativa a medicamentos que comienzan a estar anulados por mutaciones en las bacteris mediante la investigación y el desarrollo de nuevos fármacos y tratamientos. En las últimas dos décadas, apunta, algunas enfermedades han evolucionado más rápido que los tratamientos médicos.
"Si no actuamos ahora, de aquí a 20 años cualquiera que vaya al hospital para una cirugía menor podrá morir por una infección ordinaria que no podrá ser tratada con los antibióticos [de los que ahora disponemos]", ha afirmado. "Operaciones rutinarias como implatación de prótesis de cadera o transplantes de órganos podrían acabar en fallecimiento por riesgo de infección", añadió. Davies insta al Gobierno de Reino Unido o a abordar el asunto en la próxima reunión del G8 que se celebrará en Londres en abril.
ANTIBIÓTICOS DE LOS AÑOS 80
"Como sociedad global no hemos incentivado la creación de antibióticos", asegura la doctora, en declaraciones recogidas por Efe. Hoy en día se utilizan los mismos creados en la década de los 80. Para Davies, el problema estriba en que las compañías farmacéuticas no han desarrollado nuevos antibióticos desde 1987 mientras que las infecciones se han vuelto más beligerantes en este tiempo porque han generado una tolerancia a los tratamientos actuales, que han quedado anticuados.
El informe anual elaborado por el departamento de Davies calcula que 5.000 pacientes mueren cada año por infecciones en la sangre, de los cuales la mitad presentaba resistencia a los antibióticos.
También es significativo el caso de la Staphylococcus aureus resistente a los antibióticos (incluido el S. aureus resistente a la meticilina [SARM, o MRSA, por sus siglas en inglés]). Convertida en superbacteria inmune a la penicilina, se estima que es responsable de 19.000 muertes al año en Estados Unidos -más que las que causa en ese país el VIH, según datos de Reuters- y otras tantas en Europa. En el informe de Davies también se muestra preocupación por la E.coli, responsable de la "crisis del pepino" en 2011 y la Klebsiella, ambas presentes en el aparato digestivo y que pueden causar serios problemas cuando entran en la corriente sanguínea o la vejiga.
Otro ejemplo sería casos de tuberculosis resistentes a todos los medicamentos conocidos, que se han dado en los últimos años en varios países, con una mutación llamada NDM 1, que primero se identificó en la India.
La advertencia en el Reino Unido llega una semana después de que el Centro de Control y Prevención de Enfermedades (CDC) divulgara un estudio en el que se refleja que cada vez más pacientes padecen de infecciones causadas por bacterias resistentes a todos o casi todos los antibióticos.
